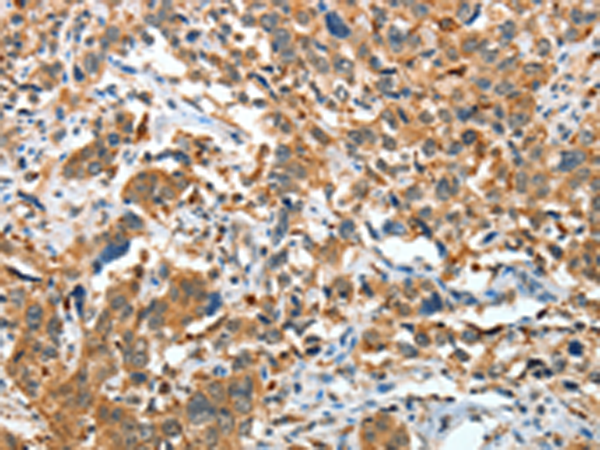
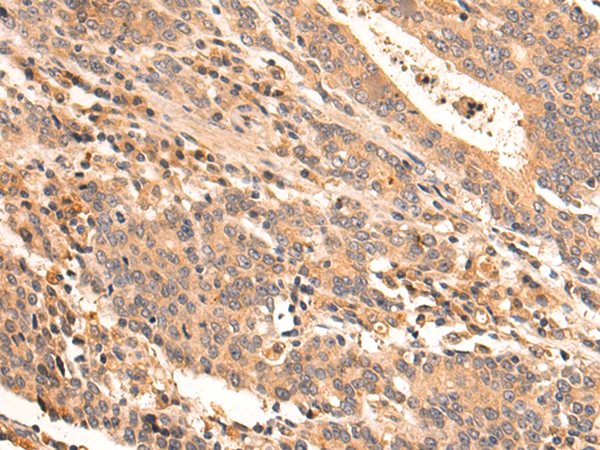
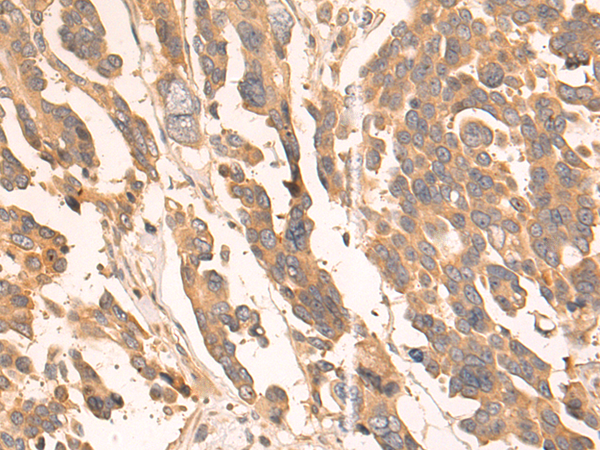

-
分类: 科研抗体货号: P07041别名: GRS; BFL1; ACC-1; ACC-2; HBPA1; BCL2L5应用: WB,IHC反应种属: Human, Mouse
-
分类: 科研抗体货号: P07050别名: CD218a; IL18RA; IL1RRP; CDw218a; IL-1Rrp; IL-18Ralpha; IL18Ralpha2; IL-18R-alpha应用: WB,IHC反应种属: Human
-
分类: 科研抗体货号: P07055别名: IL22R; CRF2-9; IL22R1应用: IHC反应种属: Human
-
分类: 科研抗体货号: P07040别名:应用: IHC反应种属: Human
-
分类: 科研抗体货号: P07049别名: SEF; HH18; IL-17RD; IL17RLM应用: WB,IHC反应种属: Human, Mouse
-
分类: 科研抗体货号: P07054别名: NILR; CD360应用: IHC反应种属: Human
-
分类: 科研抗体货号: P07067别名: A3AR应用: WB,IHC反应种属: Human, Mouse
-
分类: 科研抗体货号: P07048别名: IL17RL应用: IHC反应种属: Human
-
分类: 科研抗体货号: P07053别名: IL1R3; C3orf13; IL-1RAcP应用: WB,IHC反应种属: Human, Mouse, Rat
-
分类: 科研抗体货号: P07066别名: CGI45; PAQR1; ACDCR1; CGI-45; TESBP1A应用: WB,IHC反应种属: Human, Mouse

鄂公网安备42018502007531号
鄂公网安备42018502007531号

